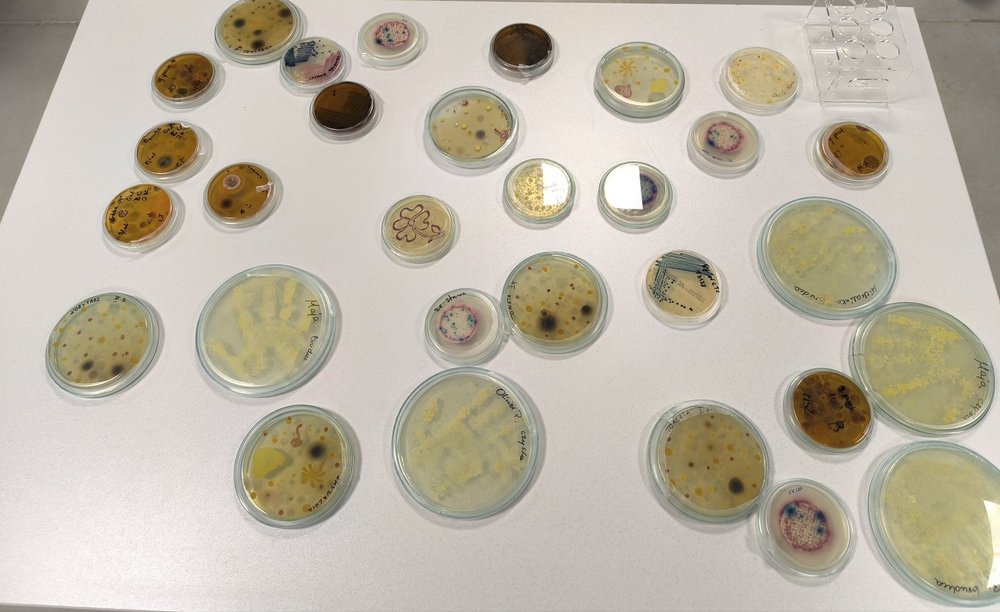
praca w laboratorium

Projekt „Mikroorganizmy w ZOO – poznajemy niewidzialnych mieszkańców.”
Projekt, realizowany przez badaczy i studentów z Uniwersytetu Łódzkiego i Uniwersytetu w Zagrzebiu zakłada cykliczne spotkania z grupami zorganizowanymi, głównie szkolnymi, realizowane na terenie ZOO Orientarium, a także organizacjach pikników naukowych na terenie Orientarium. Spotkania będą obejmować interaktywne prezentacje wprowadzające uczestników w tematykę mikroorganizmów, ich bioróżnorodności, znaczenia dla zwierząt (np. bakterie bioluminescentne) i ochrony środowiska.
Głównym wyzwaniem, którym zajmuje się projekt „Mikroorganizmy w ZOO”, jest brak powszechnej świadomości na temat mikroorganizmów i ich kluczowej roli w ekosystemach oraz w codziennym życiu. Ludzie często koncentrują się na widocznych zwierzętach, podczas gdy mikroorganizmy pozostają w dużej mierze niewidoczne i źle rozumiane, co prowadzi do nieporozumień i utraty możliwości edukacyjnych. Kolejnym wyzwaniem jest angażowanie młodych odbiorców w naukę w sposób przystępny i interaktywny, tak aby abstrakcyjne pojęcia mikrobiologiczne stały się namacalne i zrozumiałe.
W ramach projektu podjęte zostaną badania mikroorganizmów zamieszkujących środowisko ZOO poprzez zbieranie próbek, prowadzenie hodowli i analizę otrzymanych wyników. Pozwoli to uzyskać cenne dane na temat różnorodności mikrobiologicznej w przestrzeni publicznej.
Oczekiwane rezultaty obejmują nie tylko informacje naukowe o mikroorganizmach obecnych w ZOO, ale również efekty edukacyjne. Dzieci i młodzież zyskają lepsze zrozumienie mikroorganizmów, ich funkcji oraz znaczenia w przyrodzie i dla zdrowia człowieka. Projekt ma także na celu wzmocnienie współpracy między uczelnią, ZOO i społecznością lokalną, rozwijając ciekawość naukową i świadomość ekologiczną w Łodzi.
Partnerem projektu jest ZOO Orientarium Łódź – nowoczesny ogród zoologiczny, który od 2022 roku przyciąga odwiedzających unikatową ekspozycją zwierząt Azji Południowo-Wschodniej w imponującym pawilonie Orientarium — najnowocześniejszym tego typu obiekcie w Europie.
Misją Orientarium jest ochrona gatunków zagrożonych wyginięciem, wspieranie badań nad bioróżnorodnością oraz udział w międzynarodowych programach hodowlanych, co pozwala na zachowanie puli genetycznej i przywracanie gatunków do naturalnych środowisk. Placówka wyróżnia się także silnym naciskiem na edukację przez doświadczenie — interaktywne wystawy, podwodny tunel, pokazy karmienia oraz specjalne warsztaty i wydarzenia edukacyjne sprawiają, że wiedza staje się dostępna i angażująca.
ZOO Orientarium Łódź, łącząc naukę z atrakcyjną formą przekazu, umożliwia realizację działań edukacyjnych w wyjątkowym środowisku, które inspiruje do poznawania świata organizmów — w naszym projekcie: mikroorganizmów.
Projekt „Mikroorganizmy w ZOO – poznajemy niewidzialnych mieszkańców” jest ważną inicjatywą, ponieważ zwraca uwagę na niezwykle istotną, lecz niewidoczną część naszego świata – mikroorganizmy. Dzięki zbadaniu i zaprezentowaniu mikroorganizmów występujących w środowisku, jakim jest ZOO, pokażemy dzieciom, młodzieży i dorosłym niewidoczny gołym okiem element przyrody, który odgrywa kluczową rolę w zdrowiu zwierząt, ludzi i funkcjonowaniu całych ekosystemów.
Dla organizacji partnerskiej (ZOO) działania te stanowią okazję do poszerzenia możliwości nauki odwiedzających poza tradycyjną zoologię, dodając nowy wymiar zrozumienia różnorodności biologicznej. Pokazy i warsztaty nie tylko wesprą rolę ZOO jako centrum popularyzacji nauki, ale również zaangażują odwiedzających w interaktywny sposób, sprawiając, że ich wizyta stanie się bardziej wartościowa i zapadająca w pamięć.
Na poziomie lokalnym projekt wspiera rozwój świadomości ekologicznej i ciekawości naukowej. Inspirowanie młodych ludzi do poznawania mikroorganizmów i ich funkcji może pobudzić zainteresowanie nauką, medycyną czy ochroną środowiska w przyszłości. Ponadto projekt wzmacnia współpracę między uczelnią, ZOO a społecznością lokalną, pokazując, jak wiedza akademicka może wspierać edukację publiczną i rozwijać świadomość znaczenia mikroorganizmów w przyrodzie i życiu człowieka.
Zespół projektowy
- Dr Małgorzata Siwińska - Katedra Biologii Bakterii, Wydział Biologii i Ochrony Środowiska, Uniwersytet Łódzki. W pracy naukowej zajmuje się analizą produkcji zewnątrzkomórkowych polisacharydów (EPS) przez bakterie kwasu mlekowego oraz ich potencjałem w zastosowaniach przemysłowych i środowiskowych. Bada także serotypowanie pałeczek Proteus spp., ich wrażliwość na antybiotyki i związki pochodzenia roślinnego. Angażuje się w popularyzację nauki i działania edukacyjne z zakresu mikrobiologii w ramach inicjatyw IKB oraz UZO.
- Doc. dr. sc. Lucija Nuskern Karaica - adiunkt w Katedrze Mikrobiologii, Wydział Matematyczno-Przyrodniczy, Uniwersytet w Zagrzebiu. Prowadzi zajęcia z mikrobiologii oraz wirusologii. Jej badania koncentrują się na interakcjach patogenów z żywicielami oraz molekularnych aspektach mikroorganizmów. W projekcie odpowiada za wsparcie merytoryczne w zakresie doboru mikroorganizmów jako obiektów edukacyjnych oraz konsultacje naukowe i dydaktyczne.
- Aleksandra Bortniczuk - studentka II roku mikrobiologii (studia II stopnia), Wydział Biologii i Ochrony Środowiska, Uniwersytet Łódzki
- Wiktoria Jakubczyk - studentka II roku mikrobiologii (studia II stopnia), Wydział Biologii i Ochrony Środowiska, Uniwersytet Łódzki
- Kamila Kwietniewska - studentka II roku mikrobiologii (studia II stopnia), Wydział Biologii i Ochrony Środowiska, Uniwersytet Łódzki
- Antoni Łykowski - student II roku mikrobiologii (studia II stopnia), Wydział Biologii i Ochrony Środowiska, Uniwersytet Łódzki
- Wiktor Zarębski - student II roku mikrobiologii (studia II stopnia), Wydział Biologii i Ochrony Środowiska, Uniwersytet Łódzki
- Magdalena Porzuczek – studentka biotechnologii mikrobiologicznej (studia II stopnia), Wydział Biologii i Ochrony Środowiska, Uniwersytet Łódzki
- Jan Stjepan Franja - student Uniwersytetu w Zagrzebiu, Wydział Matematyczno-Przyrodniczy, Katedra Biologii
- dr Magdalena Janiszewska - pełnomocnik Zarządu ds. Nauki i Współpracy z Organizacjami Pozarządowymi, ZOO Orientarium Łódź. Koordynuje i nadzoruje projekt Science Hub UNIC w imieniu ZOO Orientarium Łódź.
Science Hub UniLodz (SH) to platforma współpracy Uniwersytetu Łódzkiego, która łączy osoby studiujące, uczelnianych ekspertów i ekspertki oraz podmioty zewnętrzne, wspierając ich w realizacji innowacyjnych projektów naukowych i wdrożeniowych. Zespoły działające w ramach SH wspólnie podejmują się rozwiązywania realnych wyzwań naukowych zgłaszanych przez organizacje partnerskie.
Projekt „We are UNIC!” jest finansowany ze środków Unii Europejskiej w ramach programu „Support for European University Alliances”, projekt NAWA FERS.01.05-IP.08-0219/23, kwota: 62,705,297.60 zł.